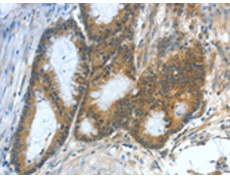
一抗

中文名稱:兔抗ASNS多克隆抗體
|
Background: |
The protein encoded by this gene is involved in the synthesis of asparagine. This gene complements a mutation in the temperature-sensitive hamster mutant ts11, which blocks progression through the G1 phase of the cell cycle at nonpermissive temperature. Alternatively spliced transcript variants have been described for this gene. |
|
Applications: |
ELISA, WB, IHC |
|
Name of antibody: |
ASNS |
|
Immunogen: |
Fusion protein of human ASNS |
|
Full name: |
asparagine synthetase (glutamine-hydrolyzing) |
|
Synonyms: |
TS11 |
|
SwissProt: |
P08243 |
|
ELISA Recommended dilution: |
1000-5000 |
|
IHC positive control: |
Human colon cancer |
|
IHC Recommend dilution: |
50-200 |
|
WB Predicted band size: |
64 kDa |
|
WB Positive control: |
Lovo and 231 cells |
|
WB Recommended dilution: |
500-2000 |


 購物車
購物車 幫助
幫助
 021-54845833/15800441009
021-54845833/15800441009